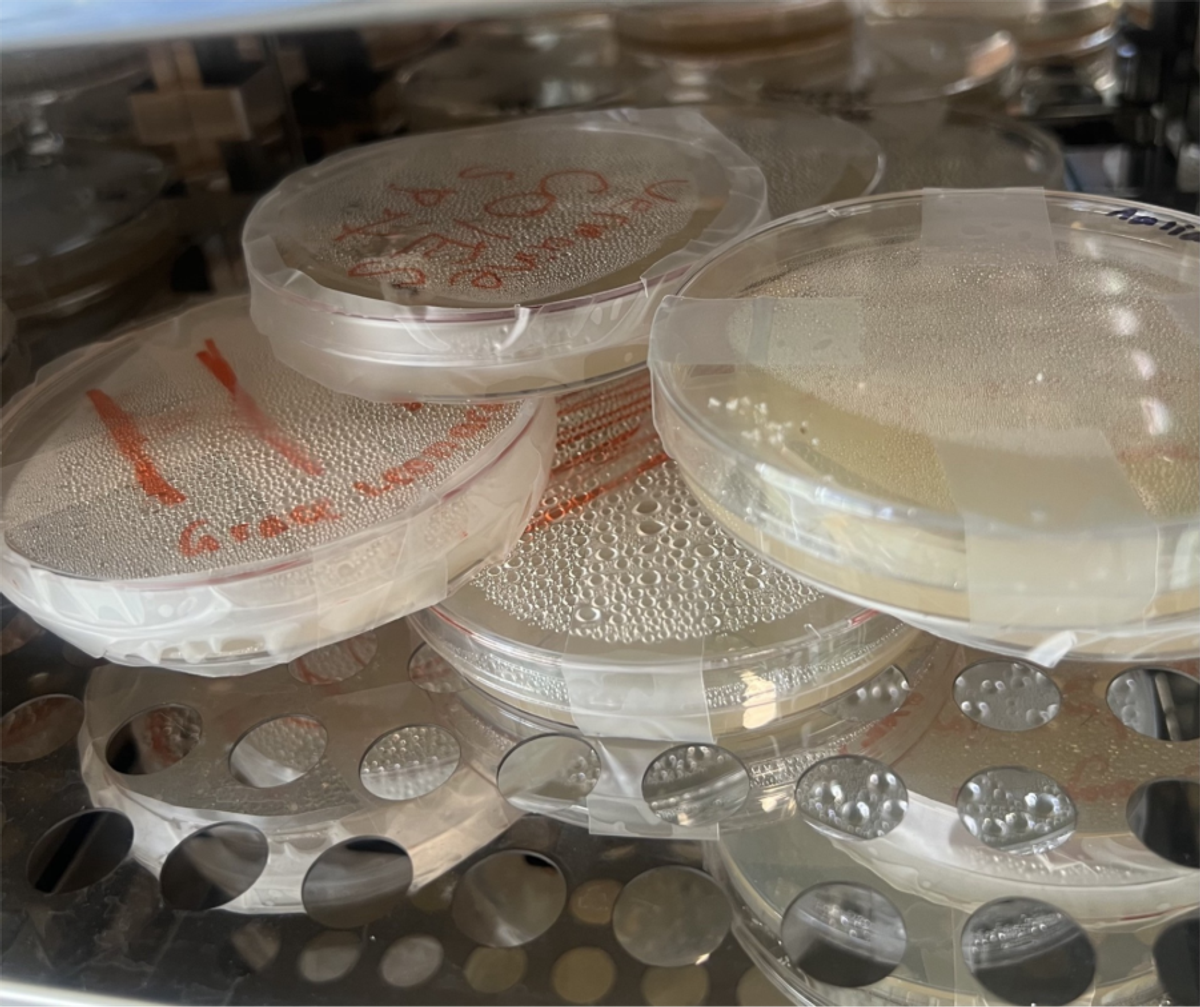
Gallery Image

Science Sparks!
- Science and Agriculture

Science Sparks!
- Science and Agriculture
This term is particularly full for our Science faculty, with assessments, excursions, and hands-on investigations across all years. Our senior students are engaging deeply in their HSC programs while juniors are working through key foundational units, in line with the NSW Science 7–10 Syllabus.
New Steers
During the holidays the farm welcomed two new Angus steers to the property. Agricultural students will learn how to feed, weigh and handle these animals as well as train them to walk on a halter.
Please welcome Waffle (grey) and Winston (black) to our farming family.


Sydney Royal Chickens
Last week we collected our new chickens for next year's Sydney Royal Easter Show School Layer competition. The six hens are 8 weeks old and will be raised and cared for by our students who will learn the skills required for maintaining their health and wellbeing.


The Year 7 cohort has been exploring the concept of classification: how scientists organise the diversity of life on Earth by grouping organisms into a hierarchical system (kingdom, phylum, class, order, family, genus, species). They have also been practising the use of dichotomous keys – tools that allow identification of organisms by a series of choices.
On November 4, Year 7 visited Sydney Zoo. Students observed a wide variety of animals and applied what they have learned in class: classifying animals, using dichotomous keys, and reflecting on biodiversity in real-life settings. The excursion reinforced classroom learning and offered memorable, practical science experiences.


Why visit the Zoo?


The excursion allowed students to see classification in action: not just worksheets, but real animals, habitats and adaptations.
It engaged students’ curiosity and helped link the abstract idea of taxonomy to the living world.
The hands-on experience supports the syllabus outcome that students “investigate the role of classification in ordering and organising the diversity of life on Earth and use and develop classification tools including dichotomous keys.”
Year 7 will continue to build on this work by creating their own classification keys (for example of Australian animals or plants) and reflecting on how classification helps scientists communicate and organise knowledge.
In Year 8, students are learning about elements, their properties, how they are arranged, and how understanding the table helps make sense of chemical behaviour. This is a key component of chemical sciences in the syllabus for Years 7–10.
Focus areas this term include:
Recognising the arrangement of elements (groups/periods) and how properties change across the table.
Understanding how the periodic table is a tool for predicting element behaviour and compounds.
Linking elements to real-world applications and materials.
This unit sets the foundation for the chemical reactions unit coming later in Year 9 and also supports scientific literacy around materials and resources.
Year 9 students are exploring chemical reactions: what they are, how to represent them (equations), the law of conservation of mass, and factors that affect reaction rates. These topics link strongly to the syllabus for Stage 5.
Highlights this term:
Hands-on experiments to observe reaction signs (gas evolution, precipitates, temperature change).
Writing word and symbolic equations to represent reactions.
Investigating real-life contexts: combustion, corrosion, acid–base neutralisation.
This work will prepare students for more advanced chemistry topics in senior years and reinforces the idea of science as investigation and explanation.
Year 10 is currently studying cell division: mitosis and meiosis, how organisms grow, repair, reproduce, and the role of cell division in inheritance and variation. This spans biology strands in the Stage 5 syllabus.
What students are doing:
Viewing slides/models of cells at various division stages.
Comparing mitosis (growth and repair) vs meiosis (sexual reproduction).
Linking cell division to health (e.g., cancer), genetics and evolution.
This unit is an important bridge into senior Biology and helps students develop scientific investigation skills: observing, modelling, comparing, and explaining.
Our Year 12 HSC Biology students are deeply engaged in the HSC course. This term they are focusing on Scientific Investigation Skills: formulating research questions, designing experiments, analysing data, and communicating findings.
A recent highlight was a flower dissection lesson: students worked hands-on to examine the reproductive structures of flowers, trace pollen pathways, identify anthers, stigma, ovules and understand fertilisation and seed formation. This practical work not only reinforces theoretical content but also supports scientific method and investigation skills.

Term 4 is a key period for growth, consolidation and celebration of science learning at Camden High. From Year 7’s immersive zoo excursion, through to Year 12’s Module 5 push in Biology, it is an exciting time where students are not only learning science: they are doing science.